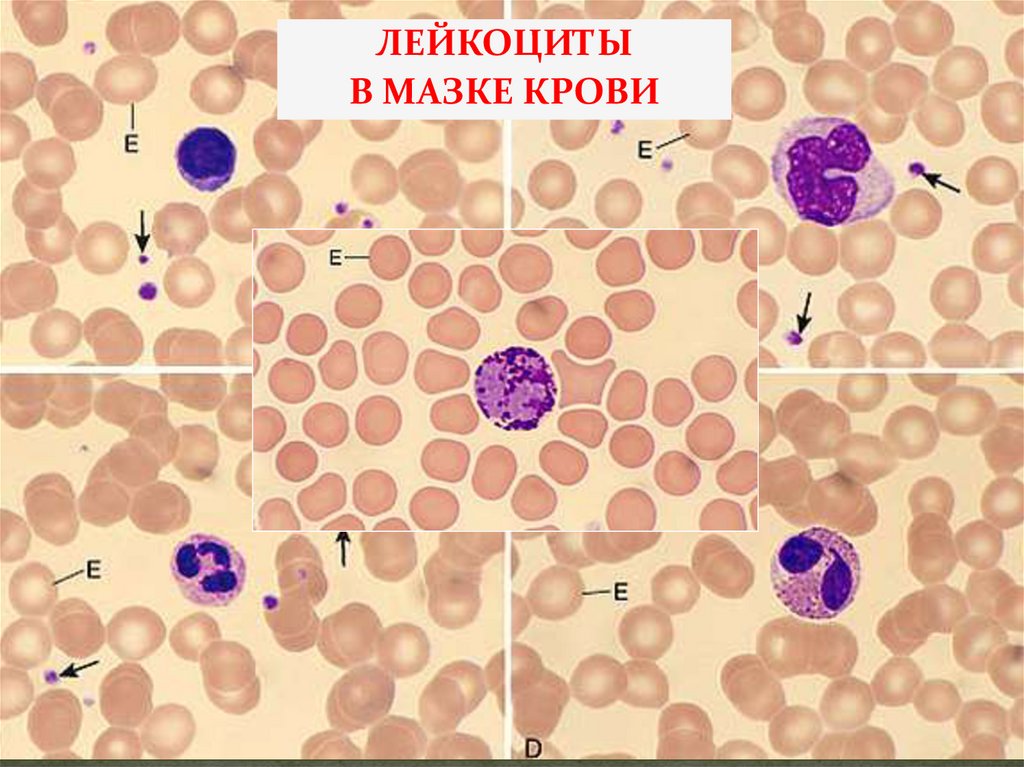
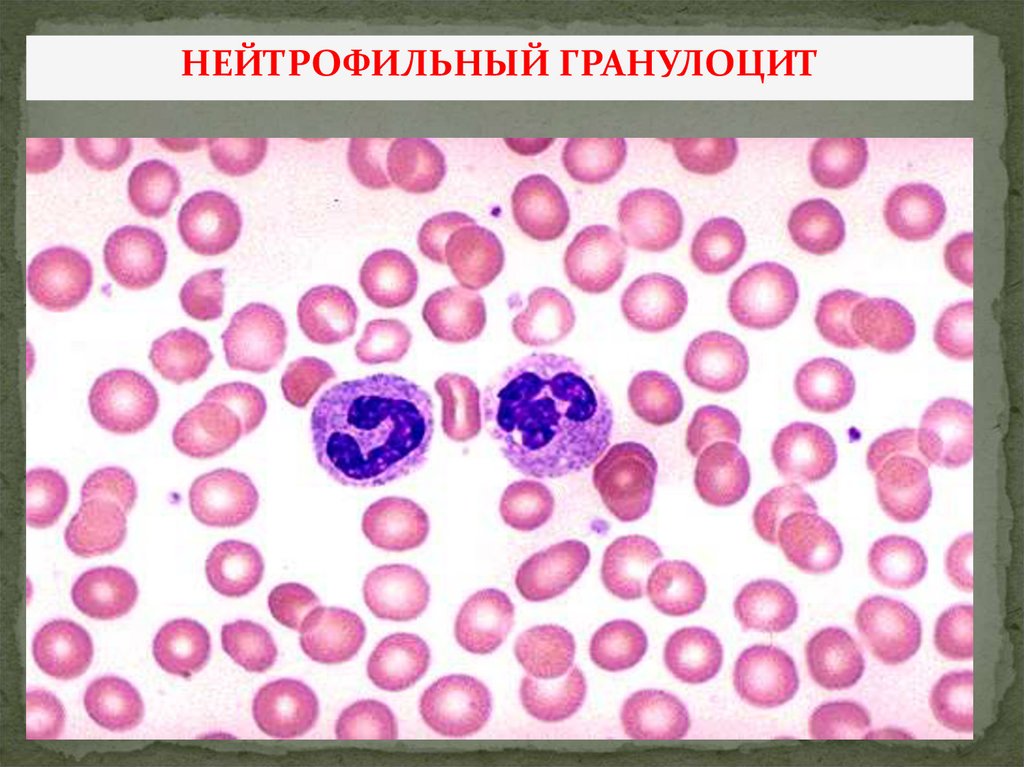
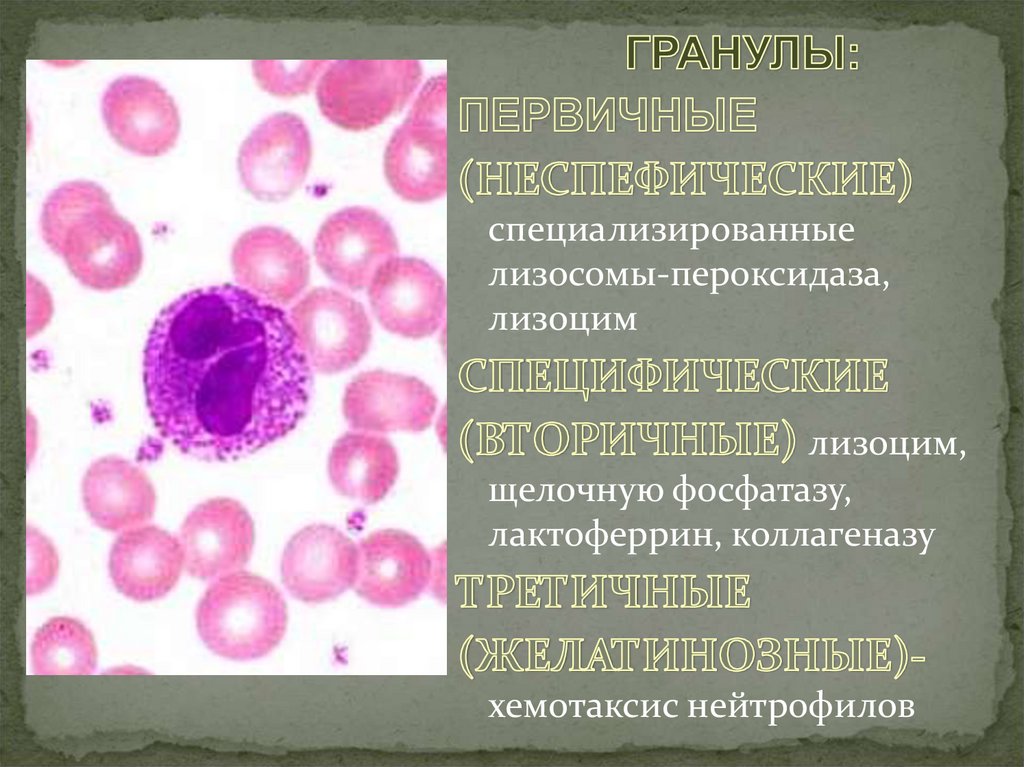
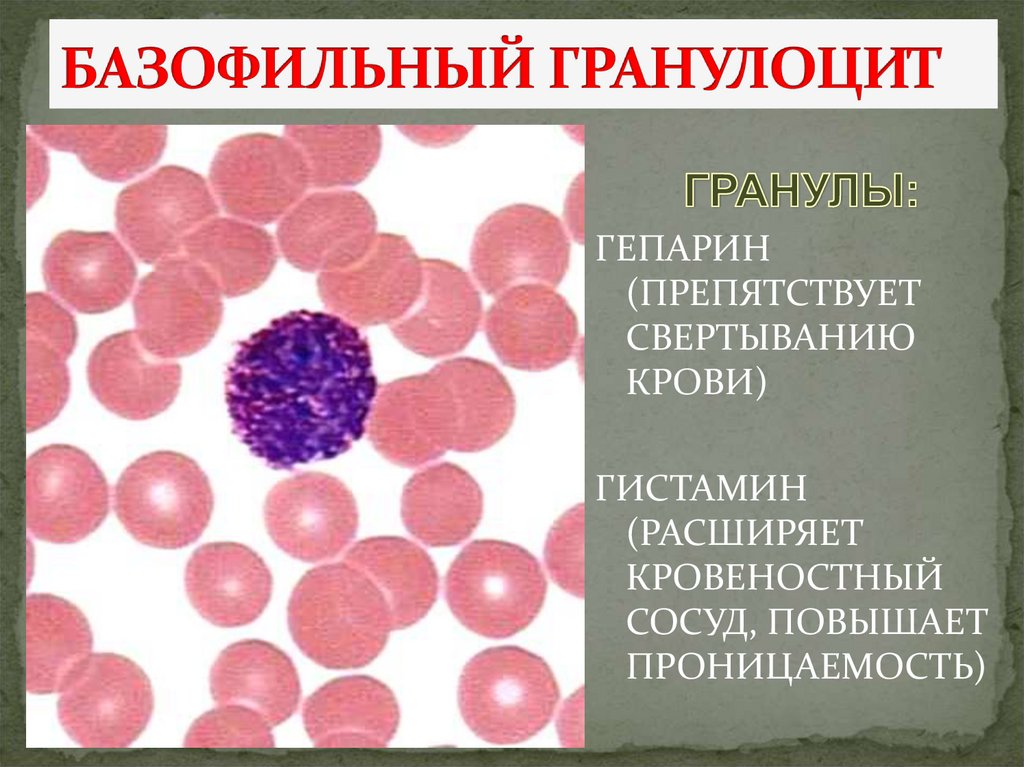
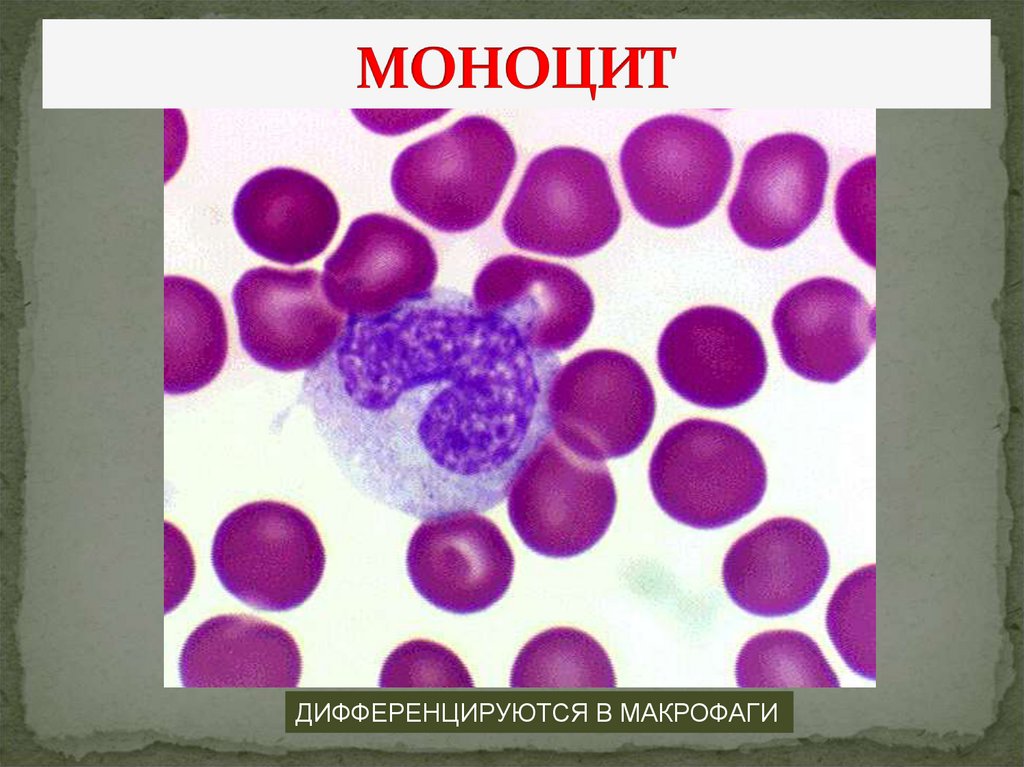
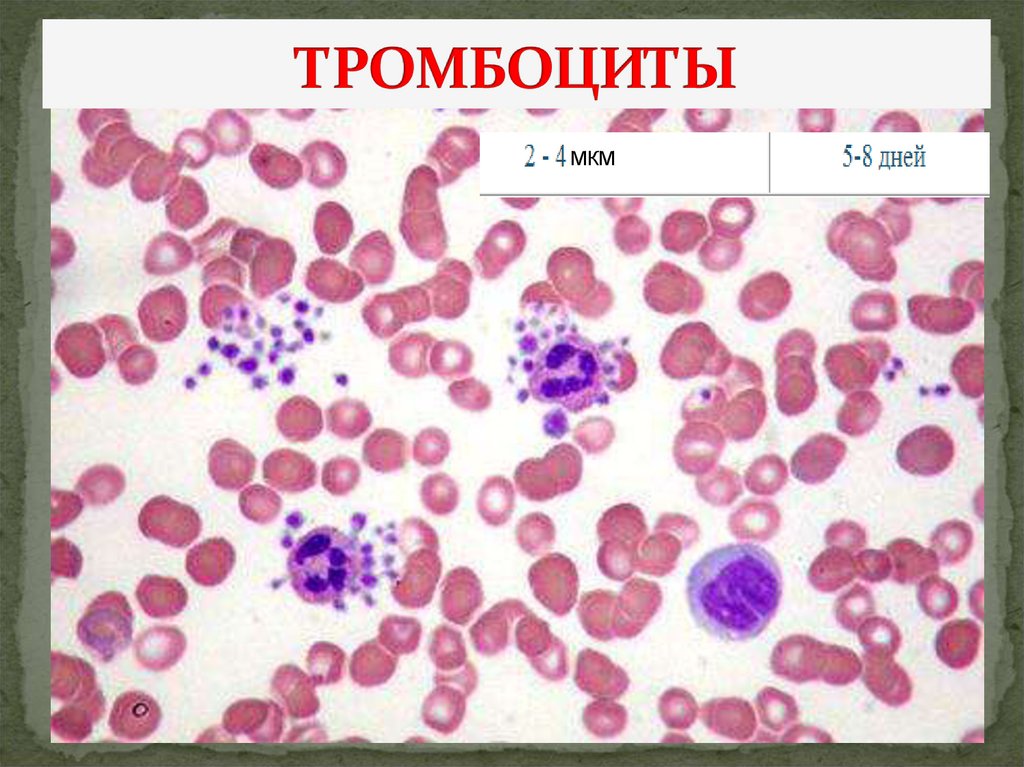

Похожие презентации:
Кровь и кроветворение
1. ТЕМА: КРОВЬ И КРОВЕТВОРЕНИЕ
1. Кровь – жидкая ткань внутренней среды.Общая морфо-функциональная характеристика.
2. Строение и функции форменных элементов.
3. Клинические показатели крови.
Гемограмма и лейкоцитарная формула.
4. Этапы кроветворения в онтогенезе.
5. Миелоидное и лимфоидное кроветворение.
2. КРОВЬ-ТКАНЬ
МЕЖКЛЕТОЧНОЕВЕЩЕСТВО
КЛЕТКИ
–
ОТНОШЕНИЕ ФОРМЕННЫХ ЭЛЕМЕНТОВ К ПЛАЗМЕ
3.
ПЛАЗМАЛЕЙКОЦИТЫ
ЭРИТРОЦИТЫ И
ТРОМБОЦИТЫ
4. ЭЛЕКТРОФОРЕЗ БЕЛКОВ ПЛАЗМЫ КРОВИ
–обеспечивают
онкотическое давление
крови
–
транспортные белки
участвуют в
свертывающей системе
крови
И др.
5. ГЕМОГРАММА схематическая запись количественных и качественных показателей форменных элементов крови в пересчете на 1 л крови.
Включает данные о количестве всех форменных элементовкрови, их морфологических особенностях, СОЭ, содержании
гемоглобина, цветном показателе, гематокритном числе…
6.
7. ЭРИТРОЦИТЫ
8.
9.
ПОЙКИЛОЦИТОЗизменение формы
эритроцитов
- СФЕРОЦИТЫ
- ПЛАНОЦИТЫ
- ЭХИНОЦИТЫ
- СТОМАТОЦИТЫ
- СЕРПОВИДНЫЕ
10.
АНИЗОЦИТОЗ - наличие в периферической кровиформенных элементов с размерами, выходящими за
пределы физиологической вариации
11. Форма и размеры определяют качество эритроцитов
12.
показывает на сколькобыстро происходит
оседание эритроцитов,
т.е. агломерация
(склеивание)
эритроцитов
13.
ПОЛИХРОМАТОФИЛЬНЫЙЭРИРОБЛАСТ
14. УЛЬТРАМИКРОСТРУКТУРА ЭРИТРОЦИТА
15.
Сканирующаяэлектронная
микроскопия
ЛЕЙКОЦИТ
16. ЛЕЙКОЦИТЫ - ИСТИННЫЕ КЛЕТКИ КРОВИ
17.
ЛЕЙКОЦИТЫВ МАЗКЕ КРОВИ
18.
19.
НЕЙТРОФИЛЬНЫЙ ГРАНУЛОЦИТ20.
специализированныелизосомы-пероксидаза,
лизоцим
лизоцим,
щелочную фосфатазу,
лактоферрин, коллагеназу
хемотаксис нейтрофилов
21.
22. СДВИГ ЛЕЙКОФОРМУЛЫ ВЛЕВО
23. ОСНОВНАЯ ФУНКЦИЯ-ФАГОЦИТОЗ
24. ЭОЗИНОФИЛЬНЫЙ ГРАНУЛОЦИТ
лизосомыпероксидазы, MBP,
эозинофильный
нейротоксин,
гистоминаза
25.
26. ОСНОВНЫЕ ФУНКЦИИ ЭОЗИНОФИЛЬНЫХ ГРАНУЛОЦИТОВ
ПРОТИВОПРОТОЗОЙНАЯ(АНТИГЕЛЬМИНТОЗНАЯ)
УМЕНЬШЕНИЕ ВОСПАЛЕНИЯ
АЛЛЕРГИЧЕСКОГО ХАРАКТЕРА
ФАГОЦИТОЗ БАКТЕРИЙ, НО В МЕНЬШЕЙ
СТЕПЕНИ
ПЕРЕВАРИВАНИЕ КОМПЛЕКСОВ АНТИГЕНАНТИТЕЛО (ИММУННЫЕ РЕАКЦИИ)
27.
ГЕПАРИН(ПРЕПЯТСТВУЕТ
СВЕРТЫВАНИЮ
КРОВИ)
ГИСТАМИН
(РАСШИРЯЕТ
КРОВЕНОСТНЫЙ
СОСУД, ПОВЫШАЕТ
ПРОНИЦАЕМОСТЬ)
28.
29.
30.
31. ОСНОВНЫЕ ФУНКЦИИ ЛИМФОЦИТОВ
В-ЛИМФОЦИТЫ – СИНТЕЗИРУЮТ АНТИТЕЛАТ-ЛИМФОЦИТЫ –РЕГУЛИРУЮТ ИММУНИТЕТ
Т-КИЛЛЕРЫ, ЗАЩИТА ОТ ГЕНЕТИЧЕСКИ
ИЗМЕНЕННЫХ СОБСТВЕННЫХ КЛЕТОК
Т-СУПРЕССОРЫ – УГНЕТАЮТ ФУНКЦИИ
РАЗЛИЧНЫХ ЛИМФОЦИТОВ
Т-ХЕЛПЕРЫ – СПОСОБСТВУЮТ
ПРОЛИФЕРАЦИИ И ДИФФЕРЕНЦИРОВКЕ
ЛИМФОЦИТОВ (ЧЕРЕЗ ЦИТОКИНЫ)
О-НУЛЕВЫЕ (НАТУРАЛЬНЫ КИЛЛЕРЫ)
32.
ДИФФЕРЕНЦИРУЮТСЯ В МАКРОФАГИ33.
34.
МКМ35.
36.
37. ОБРАЗОВАНИЕ ТРОМБОЦИТОВ
38.
39.
40.
41. МЕГАКАРИОЦИТ В ТКАНИ ЛЕГКОГО ПРИ ТРАВМЕ ККМ
42.
Периоды кроветворенияЭмбриональный (гистогенез)
Желточный
Постэмбриональный (регенерация)
2-3 неделя-3 месяц
Гепатотимусолиенальный
медуллотимусолимфоидный
5 неделя -5 месяц
2 месяц
теории
полифилетическая
унитарная
43.
44. ГЕМОПОЭЗ В СТЕНКЕ ЖЕЛТОЧНОГО МЕШКА
45.
46.
47.
ГЕМОЦИТОПОЭЗвиды
типы
миелоидное
1. Эритропоэз
2. Гранулоцитопоэз
3. Моноцитопоэз
4. Тромбоцитопоэз
лимфоидное
В-
Т-
Мегалобластическое
Нормобластическое
48. ПОЭТАПНАЯ ДИФФЕРЕНЦИРОВКА
Классы- стволовые;
- полустволовые;
- унипотентные;
- бластные;
- созревающие;
- зрелые клетки
49.
50.
51.
52.
СПАСИБОЗА ВНИМАНИЕ

Медицина
Медицина








